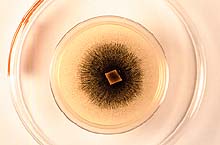

Introduction
|

Fig. 1. An article from the Fargo Forum, May 1, 1997 (click image for larger view). |
|
Stachybotrys chartarum is a fungus that has become notorious as a mycotoxin producer that can cause animal and human mycotoxicosis. Indeed, over the past 15 years in North America, evidence has accumulated implicating this fungus as a serious problem in homes and buildings and one of the causes of the "sick building syndrome." In 1993-1994, there was an unusual outbreak of pulmonary hemorrhage in infants in Cleveland, Ohio, where researchers found S. chartarum growing in the homes of the sick infants. This incident increased the awareness of home/building molds and brought this fungus to the immediate attention of the medical community. In recent years there has been a cascade of reports about toxic molds in the national media. The New York Times Magazine, August 12, 2001, ran a front page story on toxic mold. Newspaper articles (Fig. 1) such as "Fungus in 'Sick' Building" (New York Times, May 5, 1996) or "Mold in schools forces removal of Forks kids" (Fargo Forum, June 1997) are eye-catching news items. The nationally syndicated comic strip Rex Morgan ran a series on Stachybotrys, and television news shows have run entire programs on Stachybotrys contamination of homes. The fungus has resulted in multimillion dollar litigations and caused serious problems for homeowners and building managers who must deal with the human issues and remediation.
As a mycologist, I have been advising public officials and the general public on the issues concerning indoor molds. Our region experienced one of the greatest natural disasters of modern times when the Red River flooded in 1997. In Grand Forks, ND, alone, there were 9,000 flooded homes. There was an enormous need for information on the effects of the flood on human health in the Red River Valley. Because of the increasing awareness of molds in indoor air quality, a coordinated effort by city, state and federal officials to provide information on mold prevention was undertaken. In my observations following the flood and in subsequent years of dealing with indoor mold issues, I have been impressed with the common occurrence and extensive growth of S. chartarum in homes and buildings damaged by flood waters or other types of water incursions and the lack of knowledge by the general public and public and private institutions about this fungus. This review provides information on the fungus, its biologically active compounds, the history of the problem, the controversy about this fungus, and briefly comments on detection and remediation.
The Fungus
Fig. 2. A culture of S. chartarum on PDA (click image for larger view). |
|
Stachybotrys chartarum (Ehrenb. ex Link) Hughes (synonyms= S. atra, S. alternans) was first described as S. atra by Corda in 1837 (5) from wallpaper collected in a home in Prague. It is a member of the Deuteromycetes, order Moniliales, family Dematiaceae, and is common on plant debris and in soil. The taxonomic treatment of the genus by Jong and Davis (38) is a good reference on identification while Hintikka (27) provides general information on biology. The fungus grows well on common mycological media such as potato dextrose, V-8 or cornmeal agar, and sporulates profusely forming dark masses of conidia (Fig. 2). The fungus is relatively easy to identify because of the unique phialides of the genus and conidial morphology of the species. Conidiophores are determinate, macronematous, solitary or in groups, erect, irregularly branched or simple, septate, dark olivaceous, and often rough walled on the upper part. The phialides are large, 9-14 µm in length, in whorls, ellipsoid, olivaceous, and often with conspicuous collarettes. Conidia are ellipsoidal, unicellular, 7 to 12 by 4 to 6 µm, dark brown to black and often showing a ridged topography when mature. The ridged nature is readily apparent with scanning electron microscopy (Figs. 3 and 4), but can also be observed with an oil immersion lens at 1000x. On lower power the spores appear verrucose. Young spores and some mature spores may be smooth. The phialides produce conidia singly and successively into a slime droplet that covers the phialides. Eventually the slime dries and the conidia are covered with the slime residue and remain on the conidiophore as a mass or ball of spores (Fig. 3). The spores are therefore not readily disseminated in the air compared to other fungi such as Aspergillus. However, when the fungus and substrate dries and is disturbed by mechanical means or air movement, conidia can become bioaerosols. A genus similar to Stachybotrys, but with spores in chains is Memnoniella (38); it also has species that produces trichothecenes (35). Haugland et al. (21) have proposed relegation of Memnoniella to synonymy with Stachybotrys based on morphological characteristics and comparative sequence analysis of the nuclear ribosomal RNA operon.
| |

Fig. 3. The mass of conidia of S. chartarum at the tip of the conidiophore. Parts of the whorl of phialides are visible. The slime was mostly removed by the fixative. Scanning electron micrograph (click image for larger view). |
|

Fig. 4. A conidium of S. chartarum showing the ridged surface of a mature spore. Scanning electron micrograph (click image for larger view).
|
|
S. chartarum growing on natural or man made substrates can often be identified by a person familiar with its growth pattern. However, there are some very dark dematiaceous Hyphomycetes which look similar, therefore microscopic examination of the fungus is needed to confirm identification. When the fungus is actively growing, the characteristic phialides and conidia are easy to observe, but when dry, the phialides collapse, are more difficult to observe, and emphasis must be placed on morphology of conidia. Although the traditional method of identification is based on morphology of the sporulating structures, PCR primers specific for S. chartarum are reported and may now be used in commercial microbiological laboratories to identify this fungus (7,20,58). A PCR product analysis using a fluorogenic probe has also been developed to quantify conidia of S. chartarum and can be used in the analysis of samples from mold contaminated indoor environments (22,52,58).
The fungus is strongly cellulolytic and will grow under conditions of low nitrogen. A simple way to grow the fungus is to streak some conidia onto wet Whatman filter paper in a petri dish and within a week spores are produced. If spores are placed on a small ridge made in the paper, the conidiophores will grow at an angle and allow a side view of conidial formation with a stereoscope. This is a convenient method to determine if spores are in chains to distinguish Stachybotrys from Memnoniella. Also, the filter paper method will allow isolation of S. chartarum away from many other fast-growing, but non cellulolytic fungi that would out-compete S. chartarum on rich media.
Mycotoxins and Other Biologically Active Metabolites
The mycotoxins and other biologically active compounds produced by S. chartarum are of concern to human health (23,32,33,57). Mycotoxin poisoning by this fungus is referred to as stachybotryotoxicosis.
S. chartarum produces a variety of macrocylic trichothecenes and related trichoverroids: roridin E and L-2; satratoxins F, G, and H; isosatratoxins F, G, and H; verrucarins B and J; and the trichoverroids, trichoverrols A and B and trichoverrins A and B. The satratoxins are generally produced in greater amounts than the other trichothecenes, but all compounds are produced in low quantities. They apparently occur in all parts of the fungus (53). The difficulty in obtaining, identifying, and purifying these toxins has slowed extensive studies on their biological activity. Hinkley and Jarvis (23) recently published analytical methods for the identification and quantification of bioactive compounds produced by this fungus. These methods were designed to quantitate individual compounds in culture extracts and detect low levels of trichothecenes in samples.
Macrocyclic trichothecenes are highly toxic compounds with a potent ability to inhibit protein synthesis (32). Numerous studies have demonstrated the toxicity of toxins from S. chartarum on animals and animal and human cells (42,45,49,51). Yang et al. (62) reported that satratoxin G was the most cytotoxic of eight trichothecenes tested on mammalian cells, even more toxic than the well known T-2 toxin associated with alimentary toxic aleukia. Other researchers have also reported the high toxicity of satratoxins compared to other trichothecenes (18). The LD50 in mice for satratoxins is ~1 mg/kg (32).
In addition, the fungus produces nine phenylspirodrimanes (spirolactones and spirolactams) and cyclosporin, which are potent immunosuppressive agents (33). Jarvis et al. (33) suggested that the combination of trichothecenes and these immunosuppressive agents may be responsible for the observed high toxicity of this fungus. New biologically active compounds are still being discovered in cultures of S. chartarum. Hinkley et al. (24,25) recently described the metabolites atranones A-G and two dolabellane diterpenes, but the complete biological activity of these compounds is unknown. Vesper and colleagues (57,59,60) reported some isolates produce Stachylysin, a hemolysin (compounds that lyse erythrocytes), and a hydroxamate siderophore. They suggest these compounds could be pathogenicity factors involved in pulmonary hemorrhage in infants exposed to S. chartarum.
There is considerable variation among isolates of S. chartarum in the production of mycotoxins and other metabolites (2,24,27,34,40). Indeed, Hinkley et al. (25) suggest there are two chemotypes of the fungus: the atranone and the macrocyclic trichothecene producers.
History of the Problem
In the Ukraine and other parts of eastern Europe during the 1930s, there were outbreaks of a new disease in horses and other animals that was characterized by symptoms such as irritation of the mouth, throat, and nose; shock; dermal necrosis; a decrease in leukocytes; hemorrhage; nervous disorder; and death (Fig. 5) (10,14,17,26,28). In 1938, Russian scientists determined the disease was associated with S. chartarum (then known as S. alternans) growing on the straw (Fig. 6) and grain fed to the animals. Intensive studies were then conducted resulting in the first demonstrated toxicity of S. chartarum in animals. Horses were actually fed cultures of the fungus. Contents from 30 petri plates containing the fungus were fed to horses and resulted in death, while even the contents of one plate resulted in sickness. Horses seem to be especially susceptible to these toxins; 1 mg of pure toxin is reported to cause death (14). Most outbreaks were associated with hay or feed that became infested during storage under wet conditions. The Russians coined the term stachybotryotoxicosis for this new disease. Since then, stachybotryotoxicosis has been reported on numerous farm animals from various parts of the world, especially in eastern Europe, but apparently has not been reported on animals in North America (26,55,61).
|
 |
|
 |
|
|
Fig. 5. Hyperplastic dermatitis on a horse four days after feeding on straw infested with S. chartarum. Notice the scaly appearance of the upper lip area. Photograph reprinted from Sarkisov, A. Kh. 1954. Mikotoksikozi (Gribkovye otravleniia). Moscow. 216 pp. (click image for larger view).
|
|
Fig. 6. Straw contaminated with S. chartarum (top) compared to clean straw. Persons handling this heavily contaminated straw could develop stachybotryotoxicosis (click image for larger view).
|
|
In the late 1930s, stachybotryotoxicosis was reported in humans working on collective farms in Russia (10,14,17,29). People affected were those who handled hay or feed grain infested with S. chartarum or were exposed to the aerosols of dust and debris from the contaminated materials. Some of these individuals had burned the straw or even slept on straw-filled mattresses. The infested straw was often black from growth of the fungus. Common symptoms in humans were rash, especially in areas subject to perspiration, dermatitis, pain and inflammation of the mucous membranes of the mouth and throat, conjunctivitis, a burning sensation of the eyes and nasal passages, tightness of the chest, cough, bloody rhinitis, fever, headache, and fatigue. Workers developed symptoms within two to three days of exposure to the fungus. Some members of the Russian teams investigating this disease rubbed the fungus onto their skin to determine its direct toxicity. The fungus induced local and systemic symptoms similar to those observed in naturally occurring cases. The article by Drobotko (10) is a good source of information on the Russian experience with this problem.
As recently as 1977 there was an outbreak of stachybotryotoxicosis among farm workers handling infested straw in Hungary (1). The symptoms were similar to those described in Russia and began appearing about 24 hours after exposure to the fungus. One interesting result of the investigation was that S. chartarum was cultured from scraping made from symptomatic areas of the skin and from samples taken from the nose and throat. Most workers recuperated when they stopped handing the infested straw. In 1996 workers at a horticultural facility in Germany developed very painful, inflamed lesions on their fingertips followed by scaling off of the skin when they handled decomposable pots infested with S. chartartum (Fig. 7) (9). The pots were made of recycled paper.
|

Fig. 7. Pots made of recycled paper showing S. chartarum growing on the sides (notice the black blotches on the white pots). Photograph from Dill, et al., 1997. Mycoses 40:110-114. Reprinted by permission of Blackwell Wissenschafts-Verlag Berlin, GmbH. http://www.blackwell.de; http://www.blackwell.de/register/zeit_ver.htm.
(Click image for larger view.) |
|
Between the 1950s and the 1980s there were continued publications on S. chartarum but none that indicated a potential problem with S. chartarum in homes and buildings. In 1986, Croft et al. (6) reported an outbreak of trichothecene toxicosis in a Chicago home. Over a 5-year period, the family complained of headaches, sore throats, flue symptoms, recurring colds, diarrhea, fatigue, dermatitis, and general malaise. Air sampling of this home revealed spores of S. chartarum. The fungus was found growing on moist organic debris in an uninsulated cold air duct and on some wood fiber ceiling material. The home had a chronic moisture problem that favored mold growth. Extracts from the duct debris and contaminated building materials were toxic to test animals and several macrocyclic trichothecenes were identified in the extracts. When the mold problem was corrected, these symptoms associated with trichothecene toxicosis disappeared.
Since the paper by Croft et al. (6), there have been numerous reports of S. chartarum in homes/buildings in North America, but few definitive studies implicating the fungus as the primary cause of mycotoxicosis in indoor environments. One important paper by Johanning et al. (37) reported on the health of office workers in a flooded New York office building with high concentrations of S. chartarum on gypsum wall board (i.e., sheetrock). The study concluded ". . . self-reported health status indicator changes and lower T-lymphocyte proportions and dysfunction as well as some other immunochemistry alterations were associated with onset, intensity and duration of occupational exposure to toxigenic S. chartarum combined with other atypical fungi." Another intensive study by Hodgson et al. (31) described an outbreak of disease in a mold contaminated courthouse and office building. The occupants developed fatigue, headaches, chest tightness, mucous membrane irritation and pulmonary disease. The building had serious moisture problems due to various factors. Interior surfaces were heavily contaminated with S. chartarum, Aspergillus versicolor and Penicillium species, and mycotoxins were identified in moldy ceiling tiles and vinyl wall coverings. These researchers concluded that a mycotoxin-induced effect was a likely cause of disease. The primary fungus involved, however, could not be determined. Cooley et al. (4) reported on the correlation between prevalence of fungi and sick building syndrome after a long study in schools where there were concerns about indoor air quality. They concluded that Penicillium and Stachybotrys species may be associated with sick building syndrome.
In 1993-1994 a cluster of cases of pulmonary hemorrhage and hemosiderosis in infants occurred in Cleveland, Ohio. Because this is rarely observed in infants, an intensive study into the cause of the problem was initiated. There were several factors associated with this outbreak, but an important finding was that all homes of these infants had high levels of total fungi and S. chartarum (based on air and surface sampling) (8,12). Furthermore, isolates of S. chartarum from the homes were shown to produce trichothecenes (34). The homes had previously sustained water damage which resulted in the mold contamination. It was this Cleveland event that initiated the headline news of Stachybotrys. Additional evidence of the association of S. chartarum with pulmonary hemorrhage in infants has since been published (13,39,56,58). An important contribution to understanding the role of S. chartarum in this disease was the isolation of the fungus from fluid washed from the lungs of a 7 year old boy (11). The child had chronic cough and fatigue, intermittent low grade fever, and recurrent pneumonia. His home was damaged from a flood and in an area near the bedroom S. chartarum and other fungi were growing on wallpaper. The child became symptom-free when removed from the contaminated environment. This is apparently the first isolation of the fungus from human body fluids.
There is considerable controversy, however, about the role of S. chartarum in pulmonary hemorrhage in the Cleveland incident and in human health in the indoor environment (15,16,19,30,36,50,54). Some members of the scientific-medical community believe there is insufficient evidence to prove a solid causal relationship between S. chartarum and these health problems. Indeed, in 2000 the Centers for Disease Control and Prevention in Atlanta (3) published two reports critical of the study conducted in Cleveland and concluded that the association between S. chartarum and acute pulmonary hemorrhage/hemosiderosis was not proven. One of the most important areas where we lack information is the relationship between exposure to bioaerosols of S. chartartum (both in time and amount of the fungus) and effects on human health.
The possibility exists that there are multiple modes of action for S. chartarum to affect human health. Mycotoxicosis is clearly important but the immunosuppressant compounds may also have a role, although it is not clearly understood. The bioactive compounds may lead to lung dysfunction through various mechanisms (44,46). In addition, hemolytic compounds may be important, especially in infants (57). The presence of a hemolysin may lead medical investigators to view this fungus as a potential pathogen and not strictly as a mycotoxin producer. Also, the fungus could be an allergen (41). Plus, two or more of these modes may act together as suggested by Jarvis et al. (33).
Although there are many unanswered questions about the effects of S. chartarum on human health, the accumulation of data (from observations and research) over the past 65 years tells us that one should not handle materials contaminated with S. chartarum (without proper safety procedures) and strongly indicates that indoor environments contaminated with S. chartarum are not healthy, especially for children, and may result in serious illness.
Where S. Chartarum Occurs Indoors
The spores of S. chartarum are in the soil and are introduced along with flood waters or the dust and dirt entering with the water incursion. Also, building materials at the time of construction can have a coating of dust or dirt that contains S. chartarum. The fungus is most commonly found in homes or buildings which have sustained flooding or water damage from broken pipes, roof, wall or floor leaks, condensation, etc. Wet conditions are required to initiate and maintain growth. It is most common on the paper covering of gypsum wall board, but can be found on wallpaper, cellulose based ceiling tiles, paper products, carpets with natural fibers, paper covering on insulated pipes, in insulation material, on wood and wood paneling, and on general organic debris (Figs. 8 to 10). The paper covering on fiberglass insulation is another area for growth (Fig. 11). The fungus can be hidden in the ceiling, walls or floors with no or little visible evidence within the interior of the room. The spores, however, can contaminate the interior of the room through holes and cracks in the building materials (aided by negative pressure) or be transported via the air handling system. It can also be found growing in ducts if there is organic debris. Condensation due to poor design or faulty heating, ventilation, and air conditioning systems can promote growth of the fungus. The fungus will usually produce large amounts of conidiophores and conidia giving the substrate a black appearance that can be slightly shiny when fresh and powdery when dry. I have observed the fungus growing profusely on the paper covering of gypsum wall board within a week after flood water was drained from a building.
 |
|
 |
|
Fig. 8. S. chartarum growing on the back side of water damaged gypsum wall board (i.e. sheetrock) behind a basement shower stall. A high water table caused flooding in the basement (click image for larger view).
|
|
Fig. 9. Heavy growth of S. chartarum and some other fungi on gypsum wall board in a flooded school basement. This growth occurred about one week after the flood. It was removed before remodeling (click image for larger view).
|

Fig. 10. Growth of S. chartarum along the base of gypsum wall board (covering the insulation on a concrete wall) inside of a ventilation tunnel around the base of an elementary school. Notice the black areas at the base of the right side wall. The spores were being drawn up into the classrooms, thus the entire gypsum wall board had to be replaced and the tunnel sanitized. The tunnel was flooded to about 6 inches deep (click image for larger view).
|
|

Fig. 11. Growth of S. chartarum on the paper covering (arrow) of fiberglass insulation. This paper was touching the paper covering of the gypsum wall board ceiling, resulting in excessive growth of the fungus. The building had a roof leak that dripped onto the insulation and ceiling. The white ceiling is on the left. The paper is torn away from part of the fiberglass insulation (click image for larger view). |
|
Detection and Remediation
Detection of S. chartarum is usually by visual inspection and/or air and surface sampling. Because this fungus is not readily airborne compared to other fungi, air sampling in a contaminated indoor environment may show low levels of spores in the air. Also, some media used for mold evaluation of indoor air are not adequate for growth of S. chartarum. Inspection of potential sites of contamination, especially in covered and protected places, is a necessity to determine where the fungus occurs and the level of contamination. If areas contaminated with S. chartarum are discovered, do not attempt to solve the problem without following recommended safety procedures for working with toxic molds, especially if heavily contaminated. Get advice if there is a serious problem.
These are some general comments about remediation. Refer to the guidelines in the New York web site in the Author's List of Related Links. If you disturb the contaminated areas (such as tearing them out), the dust created can increase exposure to the fungus and its metabolites. Dust control can be achieved through an application of a sodium hypochlorite solution. An approved respirator, gloves, and eye and skin protection are used to handle Stachybotrys. Contaminated materials can be disposed of in plastic bags to reduce handling of infested materials. Barriers and negative pressure are used in seriously contaminated areas to vent the air outside and prevent the dust from going into non-contaminated areas of the building. Disinfecting the surface of contaminated materials, a common reaction to deal with molds, may kill the fungus on the surface, but mycelium within the substrate will often survive and grow again. Also, mycotoxins may accumulate in contaminated material (47,48). Removing contaminated materials is the best option. The paper by Vesper et al. (58) has a useful description of mold detection and remediation of a home. For more information on the assessment and control of bioaerosols see Macher (43).
Home and building owners have a myriad of questions on molds and often need basic information and straightforward advice on how to correct a problem. Fortunately, public health departments, agricultural extension services, and many internet sites now have excellent information available on molds. There are private microbiological services which can be found on the internet, and in some states public universities, extension services, or health departments can offer assistance in mold identification. Home and building owners who suspect mold problems can also acquire the services of private consultants to test for and identify molds, plus obtain advice on remediation.
To prevent indoor contamination by Stachybotrys and other molds, aggressive action to correct moisture problems must be undertaken immediately!
Further Information on Indoor Molds and Remediation
The American Phytopathologcial Society is a professional scientific society concerned with protection of plant health. We are not engineers or medical doctors and cannot provide advice on these issues. Please contact your local public health department, the CDC, or the EPA for advice on these related issues.
For more information about indoor molds and remediation, see the Author's List of Related Resources.
Acknowledgments
Thanks to the Electron Microscopy Center at North Dakota State University for the scanning electron micrographs, and to Deb Tanner for assistance with the photos. All other photos are by the author unless indicated otherwise.
References
1. Andrassy, K., Horvath, I., Lakos, T., and Toke, Z. 1980. Mass incidence of mycotoxicoses in Hajdu-Bihar county. Mykosen 23:130-133.
2. Andrienko, E. V., and Zaichenko, A. M. 1997. Certain peculiarities of biological action of the stachybotryotoxin preparations. Microbiol. Z 59(3):41-46.
3. Centers for Disease Control and Prevention (CDC). 2000. Update: Pulmonary hemorrhage/hemosiderosis among infants-Cleveland, Ohio, 1993-1996. Morb Mortal Wkly Rep 49(09):180-184.
4. Cooley, J. D., Wong, W. C., Jumper, C. A., and Straus, D. C. 1998. Correlation between the prevalence of certain fungi and sick building syndrome. Occup Environ Med 55:579-584.
5. Corda, A. C. 1837. Icones fungorum hucusque cognitorum I. Prague.
6. Croft, W. A., Jarvis B. C., and Yatawara, C. S. 1986. Airborne outbreak of trichothecene toxicosis. Atmospheric Environment 20:549-552.
7. Cruz Perez, P., Buttner, M. P., and Stetzenbach, L. D. 2001. Specific detection of Stachybotrys chartarum in pure culture using quantitative polymerase chain reaction. Mol Cell Probes 15:129-38.
8. Dearborn, D. G., Yike, I., Sorenson, W. G., Miller, M. J., and Etzel, R. A. 1999. Overview of investigations into pulomonary hemorrhage among infants in Cleveland, Ohio. Environ Health Perspect 107 (6):495-499 (Supple. 3)
9. Dill, I., Trautmann, C., and Szewzyk, R. 1997. Mass development of Stachybotrys chartarum on decomposable plant-pots made of recycling paper. Mycoses 40:110-114.
10. Drobotko, V. G. 1945. Stachybotryotoxicosis: A new disease of horses and humans. Amer. Rev. of Soviet Med. 2 (3):238-242.
11. Elidemir, O., Colasurdo, G. N., Rossmann, S. N., and Fan, L. L. 1999. Isolation of Stachybotrys from the lung of a child with pulmonary hemosiderosis. Pediatrics 104:964-966.
12. Etzel, R., Montana, E., Sorenson, W., Kullman, G., Allan, T., Olson, D., Jarvis, B., Miller, J. D., and Dearborn, D. 1998. Acute pulmonary hemorrhage in infants associated with exposure to Stachybotrys atra and other fungi. Arch Pediatr. Adolesc. Med. 152:757-762.
13. Flappan, S. M., Portnoy, J., Jones, P., and Barnes, C. 1999. Infant pulmonary hemorrhage in a suburban home with water damage and mold (Stachybotrys atra). Environ Health Perspect 107:927-930.
14. Forgacs, J. 1972. Stachybotryotoxicosis. Pages 95-128 in: Microbial Toxins. S. Kadis, A. Ciegler, and S. Ajl, eds. Volume 8, Fungal Toxins. Academic Press, New York.
15. Fung, F., Clark, R., and Williams, S. 1998. Stachybotrys: A mycotoxin-producing fungus of increasing toxicologic importance. J Toxicology Clinical Toxicology 36:79-86.
16. Fung, F., Clark, R., and Williams, S. 1998. Stachybotrys: Still under investigation. Clin Toxicol 36:633-634.
17. Gajdusek, D. C. 1953. Acute infectious hemorrhagic fevers and mycotoxicoses in the Union of the Soviet Socialist Republics. United States Army Medical Service, Graduate School, Washington D.C. Medical Science pub no. 2. Walter Reed Medical Center.
18. Glavits, R., and Vanyi, A. 1988. Effect of trichothecene mycotoxins (satratoxin H and T-2 toxin) on the lymphoid organs of mice. Acta Vet. Hung. 36:37-41.
19. Hagmann, M. 2000. A mold's toxic legacy revisited. Science 288:243-244.
20. Haugland, R. A., and Heckman, J. L. 1998. Identification of putative sequence specific PCR primers for detection of the toxigenic fungal species Stachybotrys chartarum. Molecular and Cellular Probes 12:387-396.
21. Haugland, R. A., Vesper, S. J., and Harmon, S. M. 2001. Phylogenetic relationships of Memnoniella and Stachybotrys species and evaluation of morphological features for Memnoniella species identification. Mycologia 93:54-65.
22. Haugland, R. A., Vesper, S. J., and Wymer, L. J. 1999. Quantitative measurement of Stachybotrys chartarum conidia using real time detection of PCR products with the TaqManTM fluorogenic probe system. Mollecular and Cellular Probes 13:329-340.
23. Hinkley, S. E., and Jarvis, B. B. 2001. Chromatographic method for Stachybotrys toxins. Pages 173-194 in: Mycotoxin Protocols. M W. Trucksess and A. E. Pohland, eds. Vol. 157, Methods in Molecular Biology. Humana Press, New Jersey.
24. Hinkley, S. F., Jiang, J., Mazzola, E. P., and Jarvis, B. B. 1999. Atranones: Novel diterpenoids from the toxigenic mold Stachybotrys atra. Tetrahedron Letters 40:2725-2728.
25. Hinkley, S. F., Mazzola, E. P., Fettinger, J. C., Lam, Y. F., and Jarvis, B. B. 2000. Atranones A-G, from the toxigenic mold Stachybotrys chartarum. Phytochemistry 55:663-673.
26. Hintikka, E.-L. 1977. Stachybotryotoxicosis as a veterinary problem. Pages 277-284 in: Mycotoxins in human and animal health. J. V. Rodricks, C. W. Hesseltine, and M. A. Mehlman, eds. Pathotox, Illinois.
27. Hintikka, E.-L. 1977. The genus Stachybotrys. Pages 91-98 in: Mycotoxic Fungi, Mycotoxins, Mycotoxicoses: An Encyclopedic Handbook. Vol I Mycotoxic Fungi and Chemistry of Mycotoxins. Marcel Dekker, New York.
28. Hintikka, E. -L. 1978. Stachybotryotoxicosis in horses. Pages 181-185 in: Mycotoxic Fungi, Mycotoxins, Mycotoxicoses: An Encyclopedic Handbook. Volume 2, Mycotoxicoses of domestic and laboratory animals, poultry and aquatic invertebrates and vertebrates. T. D. Wyllie and L. G. Morehouse, eds. Marcel Dekker, Inc, New York.
29. Hintikka, E.-L. 1978. Human stachybotryotoxicosis. Pages 87-89 in: Mycotoxic Fungi, Mycotoxins, Mycotoxicoses: An Encyclopedic handbook. Vol 3, Mycotoxicoses of Man and Plants. T. D. Wyllie and L. G. Morehouse, eds. Marcel Dekker, New York.
30. Hodgson, M., Miller, D., Jarvis, B., and Storey, E. 1998. Mycotoxins and building related illness-authors reply. J Occup Environ Med 40:763-764.
31. Hodgson, M. J., Morey, P., Leung, W., Morrow, L., Miller, D., Jarvis, B. B., Robbins, H., Halsey, J. F., and Storey, E. 1998. Building-associated pulomonary disease from exposure to Stachybotrys chartarum and Aspergillus versicolor. J Occup. Environ. Med. 40:241-249.
32. Jarvis, B. B. 1991. Macrocyclic trichothecenes. Pages 361-421 in: Mycotoxins and Phytoalexins in Human and Animal Health. R. P. Sharma and D. K. Salunkhe, eds. CRC Press, Boca Raton, Florida.
33. Jarvis, B., Salemme, J., and Morais, A. 1995. Stachybotrys toxins. 1. Natural Toxins 3:10-16.
34. Jarvis, B., Sorenson, W. G., Hintikka, E., Nikulin, M., Zhou, Y., Jiang, J., Wang, S., Hinkley, S., Etzel, R., and Dearborn, D. 1998. Study of toxin production by isolates of Stachybotrys chartarum and Memnoniella echinata isolated during a study of pulmonary hemosiderosis in infants. Appl. Environ. Microbiol. 64:3620-3625.
35. Jarvis, B. B., Zhou, Y., Wang, S., Sorenson, W. G., Hintikka, E.-L., Nikulin, M., Parikka, P., Etzel, R. A., and Dearborn, D. G. 1996. Toxigenic molds in water-damaged buildings: Dechlorogriseofulvins frm Memnoniella echinata. J Natural Products 59:553-554.
36. Johanning, E. 1998. Stachybotrys revisited. Clin Toxicol 36:629-631.
37. Johanning, E., Biagini, R., Hull, D., Morey, P., Jarvis, B., and Landsbergis, P. 1996. Health and immunology study following exposure to toxigenic fungi (Stachybotrys chartarum) in a water-damaged office environment. Int Arch Occup Environ Health 68:207-218.
38. Jong, S. C., and Davis, E. E. 1976. Contribution to the knowledge of Stachybotrys and Memnoniella in culture. Mycotaxon 3:409-485.
39. Knapp, J. F., Michael, J. G., Hegenbarth, M. A., Jones, P. E., and Black, P. G. 1999. Case records of the Children Mercy Hospital, Case 02-1999: A one-month-old infant with respiratory distress and shock. Pediatric Emergency Care 15:288-293.
40. Korpinen, E.-L. 1974. Studies on Stachybotrys alternans IV. Effect of low doses of stachybotrys toxins on pregnancy of mice. Acta path. microbiol. scand. Sect. B., 82:457-464
41. Larsen, F. O., Christensen, L. H, Clementsen, P., Gravesen, S., Skov, P. S., and Norn, S. 1996. Microfungi in indoor air are able to trigger histamine release by non-IgE-mediated mechanisms. Inflamm Res 45:S23-S24.
42. Lee, M.-G., Li, S., Jarvis, B. B., and Pestka, J. J. 1999. Effects of satratoxins and other macrocyclic trichothecenes on IL-2 production and viability of EL-4 thymoma cells. J. Toxicol. Environ. Health 57:459-474.
43. Macher, J. (ed.) 1999. Bioaerosols: Assessment and control. American Conference of Governmental Industrial Hygienists. Cincinnati, OH
44. Mason, C. D., Rand, T. G., Oulton, M., Macdonald, J., and Anthes, M. 2001. Effects of Stachybotrys chartarum on surfactant convertase activity in juvenile mice. Toxicol. Appl. Pharmacol. 172:21-28.
45. Mason, C. D., Rand, T. G., Oulton, M., MacDonald, J. M., and Scott, J. E. 1998. Effects of Stachybotrys chartarum (atra) conida and isolated toxin on lung surfactant production and homeostasis. Nat. Toxins 6:27-33.
46. McCrae, K. C., Rand, T., Shaw, R. A., Mason, C., Oulton, M. R., Hastings, C., Cherlet, T., Thliveris, J. A., Mantsch, H. H., MacDonald, J., and Scott, J. E. 2001. Analysis of pulmonary surfactant by Fourier-transform infrared spectroscopy following exposure to Stachybotrys chartarum (atra) spores. Chem Phys Lipids 110:1-10.
47. Nielsen, K. F., Hansen, M. O., Larsen, T. O., and Thrane, U. 1998. Production of trichothecene mycotoxins on water damged gypsum boards in Danish buildings. International Biodeterioration and Biodegradation 42:1-7.
48. Nikulin, M., Pasanen. A.-L., Berg, S., and Hintikka, E.-L. 1994. Stachybotrys atra growth and toxin production in some building materials and fodder under different relative humidities. Appl. Environ. Microbiol. 60:3421-3424.
49. Nikulin, M., Reijula, K., Jarvis, B. B., Veijalainen, P., and Hintikka, E.-L. 1997. Effects of intranasal exposure to spores of Stachybotrys atra in mice. Fundam. Appl Toxicol. 35:182-188.
50. Page, E. and Trout, D. 1998. Mycotoxins and building related illness. J Occup Environ Med 40:761-763.
51. Rao, C. Y., Brain, J. D., and Burge, H. A. 2000. Reduction of pulomonary toxicity of Stachybotrys chartarum spores by methanol extraction of mycotoxins. Appl. Environ. Microbiol. 66:2817-2821.
52. Roe, J. D., Haugland, R. A., Vesper, S. J., and Wymer, L. J. 2001. Quantification of Stachybotrys chartarum conidia in indoor dust using real time, fluorescent probe-based detection of PCR products. J Expo Anal Environ Epidemiol 11:12-20.
53. Sorenson, W. G., Frazer, D. G., Jarvis, B., Simpson, J., and Robinson, V. A. 1987. Trichothecene mycotoxins in aerosolized conidia of Stachybotrys atra. Appl. Envir. Microbiol. 53:1370-1375.
54. Sudakin, D. L. 2000. Stachybotrys chartarum: Current knowledge of its role in disease. MedGenMed, February 29, 2000.
55. Tantaoui-Elaraki, A., Mekouar, S. L., El-Hamidi, M., and Senhaji, M. 1994. Toxigenic strains of Stachybotrys atra associated with poisonous straw in Morocco. Vet Hum Toxicology 36:93-96.
56. Tripi, P. A., Modlin, S., Sorenson, W. G., and Dearborn, D. G. 2000. Acute pulmonary haemorrhage in an infant during induction of general anaesthesia. Paediatric Anaesthesia 10:92-94.
57. Vesper, S. J., Dearborn, D. G., Elidemir, O., and Haugland, R. A. 2000. Quantification of siderophore and hemolysin from Stachybotrys chartarum strains, including a strain isolated from a child with pulmonary hemorrhage and hemosiderosis. Appl. Environ. Microbiol. 66:2678-2681.
58. Vesper, S., Dearborn, D. G., Yike, I., Allan, T., Sobolewski, J., Hinkley, S. J., Jarvis, B. B., and Haugland, R. A. 2000. Evaluation of Stachybotrys chartarum in the house of an infant with pulmonary hemorrhage: quantitative assessment before, during and after remediation. J Urban Health: Bull NY Acad. Med 77:68-85.
59. Vesper, S. J., Dearborn, D. G., Yike, I., Sorenson, W. G., and Haugland, R. A. 1999. Hemolysis, toxicity, and randomly amplified polymorphic analysis of Stachybotrys chartarum strains. Appl. Environ. Microbiol. 65:3175-3181.
60. Vesper, S. J., Magnuson, M. L., Dearborn, D. G., Yike, I., and Haugland, R. A. 2001. Initial characterization of the hemolysin Stachylysin from Stachybotrys chartarum. Infect. Immun. 69:912-916.
61. Wyllie, T. D., and Morehouse, L. G. (eds). 1978. Mycotoxicoses of domestic and laboratory animals, poultry and aquatic invertebrates and vertebrates. Mycotoxic Fungi, Mycotoxins, Mycotoxicoses: An Encyclopedic Handbook. Volume 2. Marcel Dekker, Inc, New York.
62. Yang, G.-H., Jarvis, B. B., Chung, Y.-J., and Pestka, J. J. 2000. Apoptosis induction by the satratoxins and other trichothecene mycotoxins: Relationship to ERK, p38 MAPK, and SAPK/JNK Activation. Toxicol. Appl. Pharmacol. 164:149-160.
